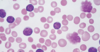
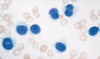
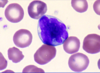
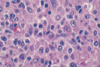
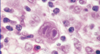
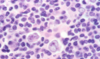
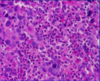
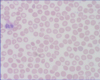
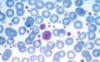
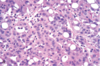

HISTOLOGY - WBC Disorder and Pulm Flashcards
(100 cards)

ALL and AML
- Scant basophilic cytoplasm
- FINE Nuclear Chromatin w/Convolutions
(Note: Unable to differentiate ALL from AML with this Histology)

Positive TdT Staining indicative of
ALL Specifically

Erythroid Precursors in
MyeloDysplastic Syndrome (MDS)
[Nuclear BIMS - Budding / irregularities / multinucleation / separation of lobes]

ProMyelocytes with AUER RODS –indicative of
aPL - Acute PROmyelocytic Leukemia
(type of AML)


Positive [MyeloPerOxidase Stain] with Dark Brown consolidation indicating
AML

Positive [AnBe Stain - Alpha napthyl Butyrate esterase] indicating
AML
(monocytic lineage)
Smudge Cells
in [CLL-SLL]

[small lymphocytes w/scant cytoplasm]
see in a lymph node of [CLL-SLL]

Hairy Cell Leukemia

Floret Cell
in
ATL - [Adult T-cell Leukemia/Lymphoma]

[Benign Reactive Follicle]
in
Follicular Lymphoma


Follicular Lymphoma
Abnormal Brown Stain in center of lymph node


Follicular Lymphoma

Mantle Cell Lymphoma
Cyclin D1 Overexpression

Burkitt Lymphoma
Starry Sky Appearance


DLBL [Diffuse Large B-cell Lymphoma]
Spleen with Fish Flush Appearance

DLBL - [Diffuse Large B-cell Lymphoma]
Multiple Nucleoli (dark structures) with
[Vesicular Chromatin - bubbly appearance]
PTCLn (Peripheral T-Cell Lymphoma - not otherwise specified)
Heterogenous Polymorphic appearance

[Hodgkins Lymphoma: Nodular Sclerosis]
Lacunar Cells
[RSO cell - Reed Sternberg OwlEye]
Hodgkins Lymphoma

[RSO cell - Reed Sternberg OwlEye] -
Mononuclear variant
in Hodgkins Lymphoma

[RSO cell - Reed Sternberg OwlEye] -
Lacunar variant
in Hodgkins Lymphoma
Popcorn RSO Variant cells
in
Hodgkins Lymphoma: Lymphocyte Predominant

[Dark Lytic Lesions] of the Skull
indicating
Multiple Myeloma